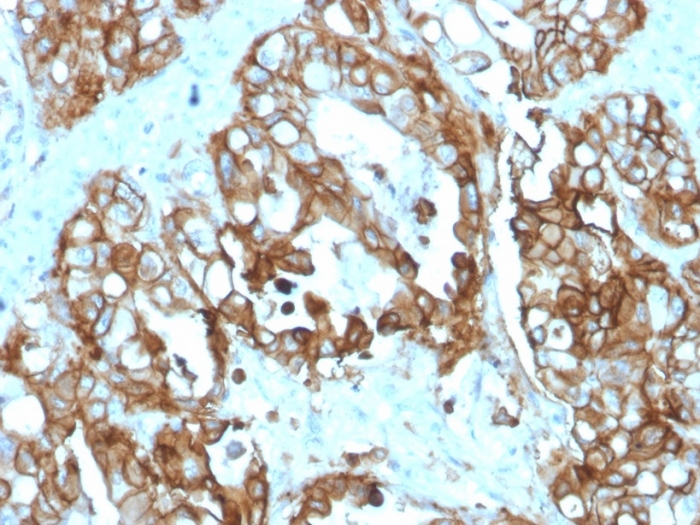

Formalin-fixed, paraffin-embedded human colon carcinoma stained with TACSTD2 Recombinant Mouse Monoclonal Antibody (rTACSTD2/6395).

Formalin-fixed, paraffin-embedded human liver in colon carcinoma stained with TACSTD2 Recombinant Mouse Monoclonal Antibody (rTACSTD2/6395).

IHC analysis of formalin-fixed, paraffin-embedded human brain. Negative tissue control using rTACSTD2/6395 at 2ug/ml in PBS for 30min RT. HIER: Tris/EDTA, pH9.0, 45min. 2°C: HRP-polymer, 30min. DAB, 5min.

SDS-PAGE Analysis of Purified TACSTD2 Recombinant Mouse Monoclonal (rTACSTD2/6395). Confirmation of Purity and Integrity of Antibody.

Western blot analysis of A-431 and MCF7 cell lysates using TACSTD2 / TROP2 (Epithelial Marker) Mouse Recombinant Monoclonal Antibody (rTACSTD2/6395).
TACSTD2 is a cell surface glycoprotein receptor. It is a single pass type I membrane protein containing one thyroglobulin type-1 domain, an epidermal growth factor-like repeat, a phosphatidylinositol binding site and tyrosine phosphorylation sites near the C-terminus. It plays a role in transducing intracellular calcium signals. It is expressed in trophoblast cells, cornea and multi-stratified epithelia. It is also highly expressed in several types of tumors and is involved in regulating the growth of carcinoma cells.
There are no reviews yet.